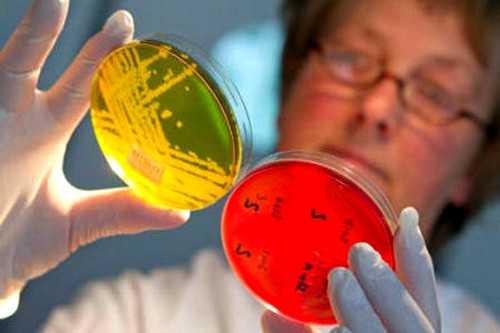

Глазные мази от конъюнктивита для взрослых и детей: что выбрать?
Конъюнктивитом могут страдать как люди в зрелом возрасте, так и маленькие дети. Поэтому для устранения данного неприятного недуга желательно подобрать специальные мази, при помощи которых можно эффективно вылечить нарывающий глаз. Лекарства лучше всего выбирать качественные, позволяющие эффективно бороться с конъюнктивитом в зависимости от его особенностей проявления.
Детский конъюнктивитВиды конъюнктивита и мази для их лечения
Заболевание может проявляться у человека в том либо ином виде. К примеру, существуют такие основные его формы, как:
- бактериальный;
- аллергический;
- конъюнктивит, полученный вирусным путем;
- контактный.
Материал по теме: Методы эффективного лечения разных форм конъюнктивита
Для бактериального конъюнктивита, лучшей мазью считается Фурацилин. Именно при помощи его люди разных возрастов могут очистить свой организм от микроорганизмов и различных инфекций. Также отлично подойдет в подобной ситуации и Тобрекс, а также Эритромициновая и Тетрациклиновая мазь.
Если человек болеет вирусным конъюнктивитом, ему можно изначально посоветовать использовать капли Альбуцид. Альбуцидом необходимо закапать оба глаза, даже если один из них является абсолютно здоровым. Лишь по истечении 30 минут с момента осуществления этой процедуры, нужно аккуратно нанести на поверхность, которая имеет раздражение, Корнерегель. Именно такой препарат наиболее эффективен для избавления от вирусной формы болезни.

Материал по теме: Обзор лекарственных средств от конъюнктивита для детей
В случае проявления аллергического конъюнктивита, оптимальным выбором считается Тобрекс, однако, она противопоказана беременным женщинам. Также можно использовать и Кортинефф при остром аллергическом воспалительном процессе.

Особенности мазей
Корнерегель представляет из себя гель прозрачного цвета. Продается в специальных тубах. Он отлично проявляет пантотеновые кислоты, необходимые на поврежденных участках ткани, но при этом не проникает глубоко в нее. В результате Корнерегель не попадает в область глазного яблока человека, но способен довольно долго находиться на поверхности участка, пораженного конъюнктивитом. Поэтому борьба с недугом в данной ситуации происходит довольно быстро.
Тетрациклиновая мазь является густой однородной массой белого цвета, которую нужно наносить тонким слоем на поверхность, пораженную конъюнктивитом.
Эритромициновая мазь способствует блокаде внутри организма возможных процессов, связанных с синтезом белка. Обладает важными антибактериальными свойствами. Основная ее функция заключается в том, что она ограничивает размножение различных бактерий и микробов.
Рекомендации по поводу правильного выбора мази
Для того, чтобы правильно подобрать мазь с целью избавления от конъюнктивита, необходимо в первую очередь получить предписание от лечащего врача, который должен четко определить диагноз и тип данной болезни. Только затем можно заниматься ее поиском в аптеках.

Детям чаще всего прописывают Флоксал, который бывает не только в виде мази, но и в виде капель. Данный препарат очень продуктивно излечивает любые воспалительные процессы, возникающие на слизистой оболочке глаза. Но к выбору мази для ребенка нужно подходить еще тщательнее, чем к аналогичному препарату для взрослого человека. Нужно учитывать его возраст и общее состояние здоровья.
Также читайте: Как выбрать капли от конъюнктивита
Если конъюнктивитом болеют взрослые люди, весьма действенными препаратами для них будут Тетрациклиновая, Левомицетиновая и Гентамициновая мази. Но очень важно подобрать качественный препарат в аптеке, следить за тем, чтобы он был аналогом необходимого лекарства. Ведь на сегодняшний день существует достаточно много подделок известных медикаментов, поэтому покупать их лучше всего в проверенных местах!
Как правильно наносить мазь
Для того, чтобы не пострадали глаза, ее нужно наносить на веки очень аккуратно. Если что-то пошло не так и лекарство раздражает слизистую оболочку глаз, их нужно тщательно промыть водой.
При использовании Тетрациклиновой мази об этом можно не беспокоиться, так как она очень мягкая и не вызывает раздражений.
Как правило, все виды мазей от конъюнктивита наносятся тонкой полоской в район нижнего века, а затем на все воспаленные участки.
При правильном лечении и соблюдении всех рекомендаций офтальмолога, избавиться от конъюнктивита можно довольно быстро. Однако, главное в этой ситуации не затягивать с процессом лечения, так как конъюнктивит с запущенной формой значительно сложнее поддается исцелению.
Читайте также:
Глазная мазь от коньюктивита у взрослых для лечения
Воспаление конъюнктивы имеет разные формы и, исходя из этого, каждый вид болезни лечится персонально. И здесь следует отметить, что лечение не ограничивается лишь применением народных методов, то есть промывании глазного яблока, но и обязательное использование лекарственных препаратов. Чтоб побороть болезнь, широко применяется глазная мазь от коньюктивита, которая напрямую борется с воспалительным процессом слизистой оболочки глаза.
Использование лекарства, чтоб вылечить коньюктивит допустимо для взрослых и детей.
Наименование препаратов при бактериальном конъюнктивите

Список мазей:
- Эритромициновая. Данная глазная мазь используется для лечения конъюнктивита среди других противомикробных средств. Положительным моментом использования заключается в том, что имеет антибактериальное действие и позволяет использовать во время лечения детей возрастом 0-12 месяцев, чтоб побороть коньюктивит. Продолжительность применения напрямую зависит от формы заболевания. Зачастую переносимость мази хорошая, но иногда наблюдается аллергическая реакция у пациентов. Не запрещается использовать при беременности и для лечения у новорожденных детей. К противопоказаниям можно отнести индивидуальную непереносимость.
- Тетрациклиновая. Предназначена для бактериального коньюктивита. В состав входит антибиотик, который обеспечивает безопасное применение данного препарата. Длительность использования зависит от стадии воспаления. Рекомендуется использовать сразу же при обнаружении симптомов конъюнктивита. К противопоказаниям относят нежелательное использование детям до 8 лет, беременным и кормящим женщинам, при наличии индивидуальной непереносимости препарата. Продолжительность применения зависит от степени воспаления. Во время использования возможно снижение резкости зрения.
- Тобрекс. Назначается при конъюнктивита инфекционного типа, в том числе бактериального. Допустим препарат к применению детям от двух месяцев. К особым указаниям следует отнести воздержание длительного применения лекарства.
Наименование мазей при вирусном конъюктивите
Список мазей:
- Флореналь. Длительность лечения обуславливается степенью воспаления слизистой глаз. Обычно при небольших воспалениях около двух недель, а что касается более тяжелого воспаления, курс может составить до двух месяцев лечения. Данный препарат не имеет строгих противопоказаний. Используется как для взрослых, так и для детей. Не запрещается в использовании беременным и женщинам, вскармливающим грудью. Единственным противопоказанием можно считать непереносимость отдельных компонентов.
- Бонафтон. Эффективно себя проявляет при лечении вирусного заболевания глаз. После применения препарата может наблюдаться снижение резкости зрения, поэтому очень важно придерживаться более спокойного рода деятельности во избежание чрезмерного напряжения концентрации глаз. Не рекомендуется использовать беременным и кормящим грудью женщинам, детям до 18 лет.
- Ацикловир. Этот препарат можно назвать одним из наиболее эффективных в отношении заболеваний слизистых оболочек глаза, которые вызваны вирусом герпеса. Действующее вещество является противовирусным, эффективно действует на коньюктивит. Противопоказанием к применению может быть индивидуальная непереносимость. Беременным и кормящим грудью женщинам, у которых обнаружен коньюктивит, принимать лишь в том случае, если нет угрозы для ребенка.
Наименование мазей при аллергическом конъюнктивите
На сегодняшний день препараты, направленные на борьбу с аллергическими реакциями разной формы богаты на ассортимент, но их применение может быть небезвредным, так как большинство могут содержать гормоны.
Список мазей:
- Тобрадекс. Мазь включает в себя состав антибиотиков, которые способствуют продуктивному лечению коньюктивита. Эффективно работает во взаимодействии с каплями: мазь применять перед сном, а капли на протяжении всего дня до четырех раз в сутки. Противопоказания заключаются в нежелательном применении детям и беременным.
- Кортинефф. Применяется при сложном воспалении слизистой глаз сопровождаются гнойным выделением. Не рекомендуется длительное применение, так как может быть вызвано повышение внутриглазного давления.
- Декса-гентамицин. Мазь глазная является антибактериальным средством широкого спектра применения. Обладает противовоспалительным, противоаллергенным и бактерицидным характером. К противопоказаниям относят аллергические реакции. Не рекомендуют к длительному применению, так как мазь может вызвать возникновение вторичных болезней.
Рекомендации по нанесению мази
Во время профилактики коньюктивита существует ряд советов, которые необходимо учесть.
- К примеру, при вирусном коньюктивите необходимо промыть глаз, перед тем как наносить мазь
- Мазь следует закладывать перед тем, как вы ложитесь спать, так как, во-первых, это намного удобней, во-вторых, большинство препаратов влияют на понижение резкости зрения.
Следует помнить, что лечение нужно начинать разумно и безопасно, ведь глаза — это один из наиболее важных органов человека. Конъюнктивит — это серьезная болезнь, и прежде чем заняться самолечением, нужно обратиться за помощью к специалисту.
Рекомендуем прочитать:
ozrenii.ru
Мазь для глаз при коньюктивите
В составе комплексного лечения коньюктивита наряду с глазными каплями часто назначают мази. С помощью специального аппликатора ее закладывают за нижнее веко, в результате на коньюктиве создается депо препарата. В результате увеличивается продолжительность его действия, а, значит, эффективность. В зависимости от состава и назначения различают противомикробные, противовирусные, противовоспалительные мази и комбинированные препараты.
Противомикробные мази
Для лечения бактериального конъюктивита применяются мази на основе антибиотиков или комбинированные с добавлением противовоспалительных препаратов.
Используются антибиотики тетрациклинового ряда, макролиды (эритромицин), фторхинолоны (офлоскацин, норфлоксацин), аминогликозимды (тобрамицин) и другие антибиотики (колистин, хлорамфеникол).

Классикой считается тетрациклиновая мазь при коньюктивите бактериального происхождения, однако в настоящее врем ее использование ограничено из-за выраженности побочных эффектов. Чаще всего применяются мази Флоксал на основе офлоскацина и Тобрекс на основе тобрамицина. Они эффективны в отношении патогенной микрофлоры и хорошо переносятся.
Мази на основе противовирусных препаратов
При вирусном поражении назначают глазную мазь от коньюктивита специфического противовирусного действия. В состав такого препарат включают синтетические интерфероны или интерфероногены. Герпетическая инфекция лечится с помощью мазей на основе ацикловира: Зовиракс, Виролекс, Ацикловир. В отношении аденовирусных и неспецифических поражений эффективны мази Бонафтон и Флореналь.

Мази с противовоспалительным действием
При тяжелых воспалительных процессах, как аллергической, так и инфекционной природы применяют мази на основе кортикостероидных гормонов. Они обладают мощным противовоспалительным действием и быстро снимают неприятные симптомы заболевания. Однако использование их ограничено из-за большого количества побочных эффектов, применять такую мазь от коньюктивита у детей нельзя.
Комбинированные препараты
Антибактериальные мази для глаз
В состав мази может входить несколько препаратов, как аналогичного действия, так и разнонаправленных.
Антибактериальная мазь для глаз при коньюктивите часто содержит несколько антибиотиков с различных спектром действия или антисептики. Например, мазь Колбиоцин содержит колистиметат натрия, хлорамфеникол и тетрациклин. В этом случае удается получить препарат с более широким спектром действия, а это важно, так как определить чувствительность патогенной флоры к антибиотику и провести индивидуальный подбор препарата не всегда возможно.
Антибактериальные и противовоспалительные препараты
Для лечения тяжелых бактериальных поражений глаз с ярко выраженными симптомами воспаления и риском возникновения органических поражений коньюктивы и роговицы используют комбинированные мази с содержанием антибиотиков или и кортикостероидных гормонов. При этом антибактериальный препарат воздействует на причину заболевания (патогенную микрофлору), а противовоспалительный агент снижает выраженности симптомов. Высокой эффективностью обладает мазь от коньюктивита у взрослых Эубетал. Помимо стероидного гормона бетаметазона, она содержит антибиотики колистин, хлорамфеникол и тетрациклин.Противовирусные препараты с антибактериальным компонентом
Противовирусные препараты часто комбинируют с антибиотиками для профилактики присоединения вторичной бактериальной инфекции при вирусном коньюктивите. Воспаленная слизистая оболочка глаза становится более чувствительной к действию патогенных микроорганизмов, а частые прикосновения к глазам из-за зуда и слезотечения увеличивают вероятность их проникновения. Использование комбинированного препарата позволяет существенно снизить риск развития осложнений.
Материалы по теме:
vashiglaza.ru
Мазь в глаза от коньюктивита для детей | Заболевания глаз
Глазная мазь от конъюнктивита для детей и взрослых
Каждой из форм конъюнктивита требуется правильно проведенная диагностика и грамотно подобранная схема терапии. Чтобы избавиться от недуга, нужно проводить симптоматическое лечение параллельно с устранением основной причины, вызвавшей заболевание.
Каким будет лечение?
Разновидности заболевания
К самым частым проявлениям конъюнктивита относят: частое слезотечение, покраснение в глазах, зуд, жжение, болезненность, отделение гнойного секрета. В зависимости от причин, которые вызвали болезнь, можно выделить такие разновидности:
1. Болезнь бактериального происхождения.
2. Аллергическая реакция на раздражители.
3. Вирусный конъюнктивит.
4. Контактный конъюнктивит.
Выбор мази
Тетрациклиновая мазь глазная при конъюнктивите назначается медиками очень часто.
Если заболевание развилось под влиянием аллергена, чаще всего назначается глазная мазь от конъюнктивита Тобрадекс ( Тобрекс ). Но следует учитывать противопоказания (период вынашивания ребенка). Для лечения аллергической формы рекомендуется также и мазь Кортинефф , особенно если воспалительный процесс острый, а симптоматика его интенсивно выражена.
Особенности использования мазей
Эритромициновая глазная мазь от конъюнктивита – это густое однородное белое вещество. Это бактериостатический антибактериальный препарат. Его применяют как противомикробное средство для избавления от разных форм заболеваний органов зрения, учитывая различные разновидности конъюнктивита. Ключевым положительным аспектом данного средства является то, что оно разрешено к применению даже детям грудного возраста. Обладает антибактериальным действием. Задачей лекарства является торможение развития и размножения активности болезнетворных микроорганизмов.
Лекарство Тобрекс — это глазная мазь. При конъюнктивите у взрослых применяется довольно часто. Содержит в своем составе антибактериальные элементы. Спектр действия лекарства широкий, это обуславливает его эффективность для устранения многих заболеваний, в том числе и конъюнктивита бактериального происхождения. Поскольку этот препарат является безопасным, при необходимости его назначаются даже для лечения детей годовалого возраста.
Менее популярные средства
Мазь Эубетал . Это комбинированный препарат, в составе которого содержатся активные антибактериальные вещества, оказывающие широкий спектр действия на возбудителей различных заболеваний органов зрения. Оказывает антиаллергический, антибактериальный эффект, устраняет воспалительные и инфекционные процессы.
Основные рекомендации по выбору препаратов
Для лечения взрослых чаще всего назначается тетрациклиновая мазь глазная от конъюнктивита. Отзывы это подтверждают. Все лекарства подбираются с учетом симптомов и степени запущенности заболевания.
Особенности использования
Немаловажным для быстрого и успешного выздоровления является правильное нанесение мазей. Наносят лекарство за нижнее веко, осторожно. Если слизистая раздражается, глаза промывают и снова наносят препарат.
http://fb.ru/article/293047/glaznaya-maz-ot-konyyunktivita-dlya-detey-i-vzroslyih
Глазная мазь от конъюнктивита для детей и взрослых
Каждой из форм конъюнктивита требуется правильно проведенная диагностика и грамотно подобранная схема терапии. Чтобы избавиться от недуга, нужно проводить симптоматическое лечение параллельно с устранением основной причины, вызвавшей заболевание.
Каким будет лечение?
Разновидности заболевания
К самым частым проявлениям конъюнктивита относят: частое слезотечение, покраснение в глазах, зуд, жжение, болезненность, отделение гнойного секрета. В зависимости от причин, которые вызвали болезнь, можно выделить такие разновидности:
1. Болезнь бактериального происхождения.
2. Аллергическая реакция на раздражители.
3. Вирусный конъюнктивит.
4. Контактный конъюнктивит.
Выбор мази
Тетрациклиновая мазь глазная при конъюнктивите назначается медиками очень часто.
Если заболевание развилось под влиянием аллергена, чаще всего назначается глазная мазь от конъюнктивита Тобрадекс ( Тобрекс ). Но следует учитывать противопоказания (период вынашивания ребенка). Для лечения аллергической формы рекомендуется также и мазь Кортинефф , особенно если воспалительный процесс острый, а симптоматика его интенсивно выражена.
Особенности использования мазей
Эритромициновая глазная мазь от конъюнктивита – это густое однородное белое вещество. Это бактериостатический антибактериальный препарат. Его применяют как противомикробное средство для избавления от разных форм заболеваний органов зрения, учитывая различные разновидности конъюнктивита. Ключевым положительным аспектом данного средства является то, что оно разрешено к применению даже детям грудного возраста. Обладает антибактериальным действием. Задачей лекарства является торможение развития и размножения активности болезнетворных микроорганизмов.
Лекарство Тобрекс — это глазная мазь. При конъюнктивите у взрослых применяется довольно часто. Содержит в своем составе антибактериальные элементы. Спектр действия лекарства широкий, это обуславливает его эффективность для устранения многих заболеваний, в том числе и конъюнктивита бактериального происхождения. Поскольку этот препарат является безопасным, при необходимости его назначаются даже для лечения детей годовалого возраста.
Менее популярные средства
Мазь Эубетал . Это комбинированный препарат, в составе которого содержатся активные антибактериальные вещества, оказывающие широкий спектр действия на возбудителей различных заболеваний органов зрения. Оказывает антиаллергический, антибактериальный эффект, устраняет воспалительные и инфекционные процессы.
Основные рекомендации по выбору препаратов
Для лечения взрослых чаще всего назначается тетрациклиновая мазь глазная от конъюнктивита. Отзывы это подтверждают. Все лекарства подбираются с учетом симптомов и степени запущенности заболевания.
Особенности использования
Немаловажным для быстрого и успешного выздоровления является правильное нанесение мазей. Наносят лекарство за нижнее веко, осторожно. Если слизистая раздражается, глаза промывают и снова наносят препарат.
http://fb.ru/article/293047/glaznaya-maz-ot-konyyunktivita-dlya-detey-i-vzroslyih
Мази от коньюктивита для детей и новорожденных
В данной публикации вы узнаете какую мазь от коньюктивита для детей и новорожденных лучше использовать в борьбе с этим неприятным заболеванием, а также научитесь правильно закладывать глазные мази.
Какую мазь, и от какого коньюктивита использовать для детей
Хотя признаки болезни всегда одинаковы, медицина определяет несколько её видов. Слизистый покров глазного яблока, век, роговицы атакуют внешние агенты разного происхождения.
Различают следующие типы поражения коньюктивитом:
Сейчас врачам известны 7 возбудителей заболевания. Каждый из них – зоологическая единица со своей особенной природой. Существует и аллергический тип болезни. Крема для лечения коньюктивита не могут быть одинаковыми.
Пользуясь случаем, рекомендуем вам препарат от давления и гипертонии #171;Нормолайф#171;. Отзывы врачей и больных доказывают об эффективности этого лекарства.
Детям школьного возраста назначается тетрациклиновая глазная мазь. Средство эффективно ликвидирует кокки. Но при вирусной или аллергической форме нужно искать другое лекарство.
Тобрамициновое лекарство уничтожает не только бактерии, но и палочки (бациллы), протеи, шигеллы. Его назначают при коньюктивите даже новорожденным. Вирусное поражение лечат мастями Флореналь, Бонафтон.
Если выявлен конкретно герпетический коньюктивит, назначают теброфеновое лекарство. Коньюктивит с аллергической природой лечат после определения источника раздражения. Хорошо снимает зуд и отёк медикамент «Эубетал».
Мази для новорожденных
Если вы хотите узнать про отзывы и состав настоя Матрёны, клацнете здесь, так как отвар Матрёны удивителен своим составом и тем, что о нём говорят.
Специальные мази для новорожденных не выпускают. Ряд препаратов подходит людям любого возраста. Это:
Даже если в инструкции к масти указано, что она безопасна для детей до 3 лет, нельзя использовать средство без указания врача.
Как правильно делать закладку глазной мази
Нижнее веко дитя тянут слегка вниз, чтобы открылась красная поверхность. На неё помещают лекарство палочкой или чистым пальцем. Ребёнку предлагают моргнуть с усилием 2-3 раза. Жировая основа лекарства расходится по глазному яблоку. Этот способ хорош для детей старше 10 лет.
Читате полезные статьи:
Кстати, а вы уже читали это:
Добавить комментарий Отменить ответ
Внимание! Информация, опубликованная на сайте, предназначена только для ознакомления. Описанные методы диагностики, лечения, рецепты народной медицины и т.д. самостоятельно использовать не рекомендуется.
Обязательно проконсультируйтесь со специалистом, чтобы не нанести вред себе и здоровью вашего ребенка!
http://helsbaby.ru/maz-ot-konyuktivita-dlya-detejj.html
Комментариев пока нет!
slovovracha.ru
Способы лечения коньюктивита глаз
При такой болезни как коньюктивит глаз лечение производится при помощи капель, мазей и средств народной медицины.
Выбор конкретного препарата будет зависеть от формы недуга и возраста пациента. Разделяют 3 формы коньюктивита: бактериальную, вирусную и аллергическую.
Лучшие капли
При лечении любой формы коньюктивита больному назначают специальные глазные капли. Если у больного обнаружена бактериальная форма данного недуга, то ему назначают Тобрекс или Ципромед
Тобрекс является препаратом, в состав которого входят антибиотики широкого спектра действия. Данные капли можно использовать для лечения коньюктивита у детей. Препарат назначают в случае, если болезнь появилась из-за воздействия стафилококковой или стрептококковой инфекции. Кроме того, Тобрекс можно использовать, если болезнь была вызвана кишечной палочкой и грамотрицательными бактериями.

В состав Ципромеда также входят антибиотики широкого спектра действия, которые способны бороться с грамоположительными и грамотрицательными микроорганизмами. Стоит отметить, что эти капли рациона использовать только для лечения коньюктивита у взрослых. Ципромед назначается детям только в экстренных случаях.
Для лечения вирусного воспаления слизистой оболочки глаза целесообразно использовать Офтальмоферон или Полудан.
Капли Офтальмоферон обладают противовоспалительным, иммуномодулирующим и противомикробным действием. Данный медикамент обычно назначается при остром течение недуга. Офтальмоферон имеет ряд противопоказаний. Среди них можно выделить беременность, период лактации и аллергию на какие-либо составляющие лекарства.

Полудан обладает сильнейшим иммуностимулирующим действием. Эти капли обычно назначаются при остром течении болезни. Стоит отметить, что Полудан назначается исключительно взрослым пациентам. Существенным преимуществом медикамента считается полное отсутствие побочных действий и относительно низкая стоимость.

Для лечения аллергического воспаления слизистой оболочки глаза пациенту назначают капли, в состав которых входят антигистаминные компоненты. Лучшими препаратами этого типа считаются Лекролин и Аллергодил.
В состав капель Лекролин входят вещества, которые подавляют выработку гистаминных соединений и купирую приступ аллергии. Этот медикамент можно применять для лечения детей в возрасте от 4 лет. Стоит отметить, что каплями Лекролин разрешено пользоваться кормящим и беременным женщинам.
Аллергодил является мощным противоотечным и антигистаминным средством. Пользоваться данным лекарством можно даже в профилактических целях. Использовать Аллергодил запрещается для лечения данного недуга у детей в возрасте до 12 лет. Беременным женщинам этот медикамент тоже не назначается.
Лучшие мази
Какая мазь от коньюктивита является наиболее эффективной? По мнению медиков, лучшими гелями являются:
- Эритромициновая мазь.
- Тобрекс.
- Бонафтон.
- Зовиракс.
- Максидекс.
Эритромициновую мазь целесообразно использовать при лечении бактериального коньюктивита. В состав медикамента входит антибиотик из группы макролидов, который подавляет рост патогенных микроорганизмов. Применять это лекарство разрешено для лечения коньюктивита у детей.

Тетрациклиновая мазь обычно используется для лечения бактериального коньюктивита у детей в возрасте от 8 лет. Существенным преимуществом лекарства является её низкая токсичность. В состав медикамента входит вещество, которое подавляет рост грамположительных и грамотрицательных микроорганизмов.
Бонафтон применяется при вирусном коньюктивите, который появился под воздействием аденовирусов или герпеса. Пользоваться этой мазью категорически запрещено детям и беременным женщинам.
Зовиракс используется для лечения вирусного коньюктивита. В состав лекарства входит вещество, которое ускоряет процесс регенерации поврежденного участка. Зовиракс не рекомендован к использованию людям с болезнями почек или неврологическими нарушениями.

Максидекс целесообразно применять для лечения аллергической формы коньюктивита. Медикамент противопоказан детям. Максидекс рекомендуется использовать в период обострения недуга. Также этим препаратом можно пользоваться в профилактических целях.
Народные средства от коньюктивита
Производить лечение коньюктивита народными средствами можно лишь в том случае, если болезнь протекает без различных обострений. Избавиться от недуга помогут листья алоэ. Из данного растения можно приготовить специальную настойку, которую можно использовать для промывания глаза. Сделать средство достаточно просто: нужно смешать 50 грамм измельченных листьев алоэ и литр кипятка. После этого нужно дать средству остыть. Наносить настойку из алоэ следует 5-6 раз в день.

Поможет избавиться от воспаления слизистой оболочки глаз настойка из черного чая. Для ее приготовления смешайте 300 грамм заваренного чая, 1 ст.л. вина и 2 ст.л. экстракта ромашки. Промывать глаза с помощью данной настойки следует 3-4 раза в день.
Хорошим средством от воспаления слизистой оболочки глаза является барбарис. Из данного растения можно приготовить специальное средство для промывания глаз. Для этого нужно смешать 1 ч.л. измельченных листьев барбариса, литр очищенной воды и 1 ч.л. чистотела. Полученную смесь нужно варить на слабом огне в течение 40 минут. После этого настойку нужно процедить. Промывайте глаза с помощью этого средства 2-3 раза в день.
antirodinka.ru
Мазь в глаза от коньюктивита
НАШИ ЧИТАТЕЛИ РЕКОМЕНДУЮТ!
Для лечения суставов наши читатели успешно используют Око-плюс. Видя, такую популярность этого средства мы решили предложить его и вашему вниманию.
Подробнее здесь…
Конъюнктивит – это воспалительный процесс, который поражает слизистую оболочку глаза – конъюнктиву. Конъюнктива глаза – это прозрачная, тонкая слизистая ткань глазного яблока. Главной функцией конъюнктивы является секреция слизистой и жидкой части слезной жидкости, которая омывает глаз. Возникновение этого воспалительного процесса связано с попаданием бактерий, вирусов, грибков, различных аллергенов на слизистую. Люди, использующие контактные линзы находятся в группе риска по возникновению конъюнктивита. Развивается заболевание глаз конъюнктивит достаточно быстро. Конъюнктивит может быть как самостоятельным, так и сопутствующим заболеванием.
Как проявляется конъюнктивит глаз, его признаки, симптомы с фото
Каким бывает конъюнктивит глаз
Конъюнктивит может быть:
— вирусным,
— бактериальным,
— грибковым,
— аллергическим.
Каждый из них имеет определенные симптомы, но есть и ряд общих, которые встречаются при любом виде конъюнктивита — это покраснение и отек конъюнктивы, повышенная чувствительность к свету, слезотечение, ощущение сухости и песка в глазах, боль в глазах.
Аллергический конъюнктивит – проявляется по-разному, в зависимости от аллергена, который является возбудителем, чаще всего это бывают лекарственные препараты, развивается в течение нескольких часов приема лекарства (еще одна причина, по которой не следует заниматься самолечением). Появляется отек конъюнктивы, боль и жжение в глазах, слизистое выделение из глаз. По клинической картине напоминает сезонный конъюнктивит, для которого характерны: повешенная чувствительность к свету, зуд и жжение в глазах, обильное слезотечение, покраснение и отек глаз, а также слизистое выделение.
Грибковый конъюнктивит — выделяют более 60 видов грибков возбудителей. В зависимости от грибка-возбудителя клиническая картина будет разной, но для всех характерно вялое течение воспалительного процесса.
Вирусный конъюнктивит — часто сопутствует поражение верхних дыхательных путей, или предшествует ему. Это может происходить при аденовирусной инфекции. Развивается в течение 7 дней. Наблюдается слезотечение, покраснение и отек конъюнктивы, может быть кровоизлияние в виде точек.
Бактериальный конъюнктивит — может возникать вследствие травмы глаза (конъюктивы), заболеваний носа, переохлаждении, обморожениях. В таких случаях создается благоприятная среда для стремительного размножения бактерий и микроорганизмов. Проявляется обильным гнойным выделением, сильным отеком век, значительное покраснение глаз.
Диагностика конъюнктивита
В диагностике конъюнктивита главную роль играет то, как развивается конъюнктивит, другими словами клиническая картина. Кроме этого собирают анамнез заболевания (когда появилась, после чего, какие препараты принимает человек, какие первые признаки, есть ли аллергия на что-нибудь и т.д.). Для выявления возбудителя берется мазок выделений из глаз.
Лечение конъюнктивита
Лечение назначается в зависимости от возбудителя и стадии развития. Очень важно правильно определить возбудителя инфекционного процесса, так как это позволит подобрать эффективное лечение с применением соответствующих лекарственных препаратов. Лечение конъюнктивита проводится комплексно с комбинированием 3-4 лекарственных препаратов в определенной последовательности.
Ни в коем случае не стоит заниматься самолечением, так как это приведет к нежелательным результатам, например, к «синдрому сухого глаза» при появлении первых признаков сразу обратится к специалистам. Как мы уже сказали, возбудителем конъюнктивита могут быть бактерии, вирусы, различных аллергенов, грибков, а значит и лечится, будут по-разному.
При бактериальном конъюнктивите — назначаются антибиотики в виде капель, предварительно проводиться определение чувствительности возбудителя к антибиотикам (левомицетин, сульфацил натрия, гентамицин, ципромед, ципрофлоксацин, тобрекс)
При вирусном конъюнктивите – назначают интерферон, например офтальмоферон.
При аллергическом конъюнктивите – назначают антигистаминные капли (опатанол, лекролин) совместно с гормональными мазями (гидрокортизон, дексаметазон)
При грибковом конъюнктивите – лекарственные препараты назначаются в зависимости от грибка-возбудителя.
Очень часто не удается точно установить возбудителя, поэтому назначается комплекс лекарственных препаратов и применяется он в определенной последовательности.
Глаз это парный орган, если воспалительный процесс проявился на одном глазу, то вскоре он проявиться и на втором, поэтому даже если у вас заболел один глаз, применять лекарственные препараты следует сразу на оба глаза.
Профилактика конъюнктивита
Надевать очки для плаванья в бассейне, после контакта с заболевшим человеком промывать глаза физ. раствором или аптечным средством для промывки (таких в аптеке множество и отпускаются без рецепта), минимально потирать глаза разве что чистый руками. Из домашних средств явно не навредит приложить чайную заварку из ромашки или черного чая. Если у вас аллергия избегайте ее причин если нет возможности узнайте у врача какое средство вам подойдет в таком случае.
Маловероятно уберечь себя хотя бы разового случая конъюнктивита, если не ходить в батискафе. Но если нашли у себя симптомы и выполнили указанные выше рекомендации все пройдет без осложнений. Будете здоровы.
Глазные капли от конъюнктивита
На сегодняшнее время в аптеках можно найти достаточно большое количество глазных капель и иных препаратов от конъюнктивита.
Все они имеют различное действие, поэтому их нельзя использовать без совета врача-офтальмолога. Глазные капли от конъюнктивита делят на три группы:
- от аллергического конъюнктивита;
- от вирусной формы конъюнктивита;
- от бактериального конъюнктивита.
Глазные капли от вирусного конъюнктивита
Для вирусной формы конъюнктивита характерно появление сильного слезоотделения и слизи в глазах, выделение которой имеет лёгкий характер.
Вирус поражает только один глаз, однако подобное заболевание может быть заразным.
В целях лечения вирусного конъюнктивита используются следующие виды капель:
«Тербофен» – 0,1% раствор, который обладает противовирусным действием. Используется по одной капле по три раза в течение дня. Иные дозы применения назначаются только лечащим врачом;
«Флореналь» – 0,1% раствор, оказывающий нейтрализующее действие на вирусы. Нужно закапывать по одной капле шесть раз день в конъюнктивальный мешок;
«Флоксал» – 0,3% раствор, который обладает антибактериальным действием. Использовать нужно по одной капле четыре раза в день. Этот препарат должен применяться на протяжении не более двух недель;
«Глудантан» – 0,1% раствор, который нейтрализует действие вирусов. Обычно используется по одной капле от одного до трёх раз в день. В случае, если конъюнктивит имеет сложную форму, дозировку увеличивают до шести капель в сутки;
«Офтадек» – 0,02% раствор, оказывающий антисептическое действие, используется до пяти раз в сутки по три капли. Если требуется иная схема применения, то она обосновывается лечащим врачом-офтальмологом;
«Альбуцид» – 30 или 20% раствор, противомикробное лекарственное средство, снимающее симптом покраснения. Препарат используется три раза на протяжении дня по одной или две капли. Отрицательным эффектом является появление жжения, которое ощущается ещё определённое время после применения глазных капель, поэтому для детей рекомендовано закапывание двадцати процентного раствора, для взрослых – тридцатипроцентного раствора;
«Тобрекс» – 0,35 раствор, являющийся сильным бактерицидным антибиотиком широкого спектра действия. Способ применения и дозировка определяются течением заболевания, и назначает данные глазные капли исключительно врач-офтальмолог.
Глазные капли от бактериального конъюнктивита

В отличие от вирусной формы бактериальный конъюнктивит, поражает оба глаза, кроме того для него характерно выделение слизи. Он также может передаваться от больного человека здоровым личностям. Для его устранения используются:
«Норсульфазол» – десятипроцентный раствор. Перед его использованием необходимо промыть глаза, капать по одной или две капли на протяжении суток три раза;
«Альбуцид» – 30 или 20% раствор, противомикробное лекарственное средство, снимающее симптомы гиперемии (покраснения). Препарат используется три раза на протяжении суток по одной или две капли в конъюнктивальный мешок. Для детей рекомендуется использовать только 20%-й раствор, для взрослых – 30%-й раствор;
«Гентамицин» – 0,25% раствор. Эти глазные капли имеют эффект который подобен лекарственному средству «Левомицетин». Препарат обладает выраженным антибактериальным действием, однако лечение им может назначаться только лечащим врачом-офтальмологом, он также определяет дозировку и способ использования;
«Левомицетин» – 0,25% раствор. Данный препарат обладает антибактериальным эффектом, однако для избегания побочных эффектов необходимо проконсультироваться со специалистом перед его использованием, который и назначит дозировку и способ применения;
сульфат цинка в растворе также может применяться в качестве капель для глаз. Концентрацию определяет врач, стандартно этот показатель равняется 0,25 %, в случае острого течения заболевания концентрация может увеличиваться до 1%. Данное лекарственное средство закапывается три раза в течение суток, однако обязательно через равные промежутки времени;
«глазные капли «Офтадек», «Флоксал» и «Тобрекс» так же как и при вирусном конъюнктивите, могут использоваться при бактериальной форме данного заболевания.
Рекомендуем статью по схожей тематике: Солкосерил гель инструкция по применению.
Узнать про ночные линзы для коррекции зрения, вы можете из этой публикации.
Лечение и профилактика близорукости у детей, подробно освещены здесь.
Глазные капли от аллергического конъюнктивита
Причиной развития аллергического конъюнктивита чаще всего являются внешние раздражители: пыльца цветущих растений, запахи, пыль. При этом наблюдается покраснение век, сильный зуд глаз, выделение гноя. Для лечения данной формы конъюнктивита наиболее распространены следующие капли:
«Кларитин» – препарат, который имеет выраженное противоаллергенное действие. Он применяется по одной капле три раза на протяжении суток;
«Кортизон» – данное лекарственное средство нужно использовать с крайней осторожностью, предварительно необходима консультация лечащего врача. Противопоказано применение данных глазных капель в период беременности;
«Лакрисифин» – противоаллергенный препарат, действующий несколько сильнее лекарственного средства «Кларитин»;
«Офтадек» – препарат, который отлично помогает не только при бактериальных и вирусных формах конъюнктивитов, но и при наличии данного заболевания.
Хронический конъюнктивит можно назвать наиболее тяжёлым патологическим состоянием. Чаще всего он возникает у взрослых людей. Причинами его развития можно назвать длительное действие внешних раздражителей на органы зрения: дым, пыль, различные химические примеси воздуха. Это патологическое состояние тяжело поддаётся лечению, оно может длиться длительное время.
НАШИ ЧИТАТЕЛИ РЕКОМЕНДУЮТ!
Для лечения суставов наши читатели успешно используют Око-плюс. Видя, такую популярность этого средства мы решили предложить его и вашему вниманию.
Подробнее здесь…
Капли при конъюнктивите
Современная фармацевтика производит огромнейшее количество всевозможных глазных капель. Но капли при конъюнктивите используются определенные. Их также существует большой ассортимент, который делится на группы по показаниям и типу конъюнктивита. Глазные капли должны подбираться с особой тщательностью и осторожностью, поэтому они назначаются только лечащим врачом. Также капли есть специально для детей и для взрослых. Так как конъюнктивит бывает трех основных видов, то и препараты подбираются соответствующие.
Основные виды конъюнктивита
- Аллергический конъюнктивит считается неинфекционным, поэтому он не передается никаким путем. Основной причиной развития являются всевозможные аллергены. К раздражителям относится пыль, пыльца растений, продукты питания, шерсть животных, перья птиц, бытовые химикаты, вещества в духах и косметических средствах, многое другое. Поражается одновременно оба зрительных органа.
- Бактериальный конъюнктивит развивается на фоне инфицирования различными бактериями. Это может быть гонококк, стрептококк, хламидии, стафилококк и так далее заболевание заразное. Передается воздушным, капельным, контактным и половым путем. Инфицироваться можно в любом месте большого скопления людей, бассейне, Ване, сауне, больнице, детских учреждениях и при контакте с больным человеком. Бактерии считаются довольно устойчивыми к любым неблагоприятным условиям, поэтому они длительное время могут сохранять жизнеспособность даже на обычных предметах. Например, детских игрушках, полотенце, постельном белье, носовом платке и так далее. Бактериальная форма может обнаружиться даже у новорожденного, так как заражение происходит в момент родов. Но это возможно только в том случае, если мама болеет гонореей или хламидиозом.
- Вирусный тип передается воздушно-капельным путем. Среди возбудителей чаще всего встречается герпес, аденовирус, эховирус, микроорганизмы простудных заболеваний.

Глазные капли при аллергическом конъюнктивите у детей
Противоаллергические глазные капли при конъюнктивите для детей:
- «Кортизон» относится к гормональной группе, поэтому применяется только по назначению доктора. Обладает высокой степенью эффективности, как противоаллергическое и противовоспалительное средство.
- «Аллергодил» можно использовать с 4-х лет. Обладает длительным действием, практически не имеет побочных действий.
- «Опатанол» применятся, начиная с 3-х лет. Побочные реакции возникают крайне редко, благодаря чему можно использовать достаточно длительное время.
- «Лекролин» используется с рождения. Основным компонентом является натриевая соль кромоглициевых кислот.
- «Левокабастин» назначается только по достижению 12-ти лет.
Глазные капли при вирусном конъюнктивите у детей

Капли в глаза при конъюнктивите вирусном:
- «Офтальмоферон» быстро устраняет симптомы воспалительного процесса, нейтрализует вирус. Побочных реакций практически нет.
- «Альбуцид» считается самым востребованным, так как обладает несколькими свойствами: уничтожает вирусы и бактерии одновременно. При применении обязательно учитывается возраст ребенка.
- «Дексаметазон» так же относится к популярным глазным каплям. Обладает максимально быстрым действием. Однако использовать капли более 2-х недель не разрешается.
- «Тобрекс» применяется, начиная с рождения. Побочных реакций не отмечается.
- «Флореналь» считается довольно эффективным препаратом. Но есть одна побочная реакция – жжение в глазках после закапывания.
Глазные капли при бактериальном конъюнктивите у детей
Глазные капли при конъюнктивите бактериальном:
- «Левомицетин» относится к антибиотикам. Побочных реакций нет, но возможна аллергия на компоненты.
- «Фуциталмик» так же может вызвать аллергическую реакцию.
- «Интерферон» считается самым безопасным для деток, особенно новорожденных.
- «Флоксал» не имеет побочных реакций и не вызывает аллергии.
Глазные капли при вирусном конъюнктивите у взрослых
Противовирусные капли при конъюнктивите у взрослых:

- «Теброфен» используется исключительно 1%-ый. Капать рекомендовано трижды в сутки по капле.
- «Флореналь» закапывается до 6-ти раз в сутки.
- «Флоксал» дополнительно нейтрализует бактерии. Капать допустимо максимум 4 раза в день. Запрещено использовать больше 2-х недель.
- «Глудантан» применяется максимум 3 раза в день.
- «Офтадек» назначается в самых запущенных случаях и острых формах. Применяется до 6-ти раз в день.
- «Альбуцид» быстро устраняет симптоматику и нейтрализует вирусы, бактерии.
- «Тобрекс» относится к группе антибиотиков, поэтому имеет широкий спектр действия.
Глазные капли при бактериальном конъюнктивите у взрослых
Антибактериальные капли от конъюнктивита – лечение у взрослых:
- «Альбуцид» в короткие устраняет симптомы и нейтрализует бактерии. Закапывать трижды в сутки по дозировке, назначенной доктором.
- «Норсульфазол» рекомендовано закапывать трижды в день по 2 капли.
- «Тобрекс» относится к антибиотикам.
- «Гентамицин» во многом схож с препаратом «Левомицетин». Обладает мощными антибактериальными действиями.
- «Левомицетин».
- «Флоксал».
- «Офтадек».
Глазные капли при аллергическом конъюнктивите у взрослых
Противоаллергические капли при конъюнктивите:
- «Кларитин».
- «Кортизон».
- «Офтадек».
- «Лакрисифин».
- «Опатанол».
- «Аллергодил».
- «Гистимет».
- «Кромогексал».
- «Лоратадин».
- «Цитрин».
- «Телфаст».
- «Зиртек».
- «Азеластин».
- «Кром-Аллерг».
Важные рекомендации
Категорически запрещено заниматься самостоятельным лечением и применять капли на свое усмотрение. Дело в том, что даже самый безобидный аллергический конъюнктивит подразделяется на несколько видов, в зависимости от типа аллергена. Что уж говорить о вирусной форме и бактериальной! Поэтому для каждого вида и подвида конъюнктивита применяются разные глазные капли. К тому же многие препараты имеют противопоказания и побочные реакции, а организм каждого человека индивидуален.
Если глазные капли, которые назначит врач, окажутся слишком дорогостоящими, попросите доктора выписать вам более дешевые аналоги. Поверьте, их много. В крайнем случае, вам необходимо узнать основное действующее вещество капель, на основании которого нужно подбирать аналог.
Своевременно обращайтесь к офтальмологу, потому что такое заболевание, как конъюнктивит, может привести к серьезнейшим осложнениям. Например, офтальмологическим патологиям и даже слепоте.
Всегда строго соблюдайте все предписания специалиста.
1ozrenii.ru
Мази для глаз от конъюнктивита для детей и взрослых — что выбрать
Мазь от коньюктивита подбирают в зависимости от типа заболевания. Это делается индивидуально для каждого случая возникновения недуга. Мазь от коньюктивита для детей практически ничем не отличается от подобного лекарства для взрослых. Препарат назначается врачом, самостоятельное применение этих медикаментов запрещено.
Содержание статьи

Крем при бактериальном конъюнктивите
Для лечения болезни этого типа часто применяют Фурацилин. Это средство очищает пораженные места от бактерий при конъюнктивите. Лечение эти препаратом дает хорошие результаты. Для устранения бактериальной формы недуга используют следующие мази:
- Препарат на основе эритромицина.
- Крем с тетрациклином.
- Медикаменты Эубетал, Колбиоцин, Тобрекс.
Эритромициновая мазь для глаз от коньюктивита пользуется наибольшей популярностью среди подобных ей препаратов. Производится в тюбиках разного объема (от 3 до 10 г). Ее можно применять для лечения младенцев. Противопоказан препарат при чувствительности к основным компонентам и болезнях печени.
Лечение бактериального типа болезни можно проводить с использованием крема на основе тетрациклина. Медикамент безопасен, но его нельзя применять детям до 8 лет.
При бактериальном конъюнктивите тетрациклиновая мазь помогает из-за наличия в ней антибиотика, который убивает большинство микроорганизмов.
Для устранения болезни у взрослых лечение можно производить мазью Тобрекс. Препарат продается в тюбиках по 3,5 г. При ячмене, кератите, конъюнктивите мазь устраняет инфекционное поражение. Положительным качеством препарата является возможность его применения для лечения малышей в возраст е от 2 месяцев.
Такая глазная мазь при коньюктивите, как Колбиоцин, позволяет быстро излечить недуг, так как в ее состав входят тетрациклин и еще несколько химических соединений, убивающих микроорганизмы. Выпускают лекарство в тюбиках весом 5 г. Этот медикамент позволяет лечить гнойные воспаления, конъюнктивит катарального типа. Противопоказан детям до 7 лет и будущим матерям.
Высокой эффективностью отличается препарат Эубетал. Его продают в тюбиках объемом 3 г. В состав лекарства входит тетрациклин и другие антибактериальные соединения. Уничтожает не только микроорганизмы, но и амебы, микоплазмы, убивает хламидии. Противопоказан медикамент при высоком давлении внутри черепа, при болезнях роговицы и повышенной чувствительности к ингредиентам лекарства.
Кремы против вирусного конъюнктивита
Если у больного диагностирован вирусный коньюктивит глаз, то врачи рекомендуют перед нанесением на больное место глазной мази промыть глаза настойкой ромашки или чая. Таким образом, обрабатывается не только сам глаз, но и область вокруг него. Этого нельзя делать, если у человека аллергия на указанные настойки.
Лечить вирусный тип заболевания можно такими препаратами, как:
- Альбуцид (капли).
- Растворы с интерфероном.
Если болен ребенок, то лечение лучше провести следующим образом. Сначала промывают глаза настойкой ромашки. После этого через 15 минут можно закапать Альбуцид. Лекарство вносят в оба глаза. Это делается даже в том случае, если один из них здоровый. После указанной процедуры на зону вокруг больного глаза наносят тетрациклиновую мазь.
Если нет Альбуцида, то лечение можно провести растворами или каплями, в которые входит интерферон. Такие препараты уничтожают вирусы. Их закапывают в оба глаза. Через полчаса после этой процедуры на зону вокруг больного места надо нанести мазь, которую выписал лечащий врач.

Иногда при вирусном конъюнктивите используется такой медикамент, как Мурамистин. Но лучше это делать только при указании врача, так как лекарство может нанести ожог слизистой оболочке глаза. Чаще всего это происходит при использовании раствора с сильной концентрацией лечебного компонента.
Борьба с аллергической формой болезни
Это наиболее тяжелая форма заболевания, которая может сочетаться с бактериальной или вирусной формой конъюнктивита. Бороться с таким заболеванием сложно, так как надо точно выявить аллерген, воздействие которого поразило глаза. После того как это будет сделано, врач назначит антигистаминные препараты и капли для лечения глаз. Мази, в которых сочетаются оба вида медикаментов, широко применяют для устранения этого вида недуга. Чаще всего употребляются препараты Тобрадекс и Кортинефф.
Первый медикамент содержит в своем составе такие мази, как Тобрамицин и Дексаметазон. Входят в него и некоторые антибиотики, что позволяет быстро уничтожить вирусы и бактерии. Но Тобюрадекс нельзя использовать для лечения беременных женщин и детей любого возраста.
При аллергическом конъюнктивите врач может выписать мазь Кортинефф. Она эффективна при наличии у больного острого кератита аллергического происхождения. Хорошо справляется этот медикамент и с заболеваниями глаз, сопровождающихся воспалением.
Лекарства, применяемые совместно с мазями
Вылечить болезнь возможно при использовании комплексного подхода. Поэтому врачи выписывают не только мази, но и глазные капли. При вирусном типе болезни используются такие препараты, как Полудан, Актипол и им подобные.
Аллергический конъюнктивит можно излечить, если совместно с указанными выше мазями использовать капли для глаз, например, Кромогексал, Аллергодил и др.
Если у больного диагностирован бактериальный конъюнктивит, то врач может выписать совместно с мазью антибиотики.
Для промывания глаз перед нанесением мази употребляют Фурацилин или Мирамистин. Они позволяют очистить пораженную недугом зону от пыли и бактерий. Мирамистин лучше всего использовать для лечения взрослых, так как у детей он может вызвать ожоги слизистых.
Для предотвращения заболевания можно в качестве профилактики использовать время от времени глазные капли. Нельзя допускать попадания в глаза аллергенов и инородных предметов. Лучше чаще промывать органы зрения настойкой ромашки или чая.
Видео
o-glazah.ru